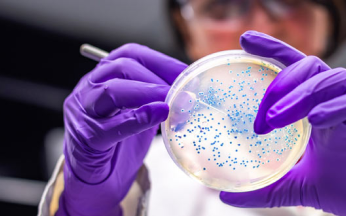
Kanti Labs: Chemical Testing

Welcome to Kanti Lab Services Pvt Ltd. We are a leading provider of comprehensive food testing services, offering a range of analytical tests to ensure the safety and quality of your food products.
Our state-of-the-art laboratory is equipped with the latest technology and staffed by experienced food scientists who are dedicated to providing accurate and reliable results. We follow strict quality control procedures to ensure that all tests are performed to the highest standards.

Our Services.
We offer a wide range of food testing services, including microbiological analysis, chemical analysis, and nutritional analysis. Our services are designed to help you ensure the safety and quality of your products, meet regulatory requirements, and protect your brand reputation.

CHEMICAL TESTING
MICROBIOLOGICAL TESTING

SHELF LIFE TESTING

HYGIENE MONITORING

RESEARCH & DEVELOPEMNT
Why Choose Kantilab ?
Accreditations & Certifications.
We are humbled to announce that we are now accredited by National Accreditation Board for Testing and Calibration Laboratories (NABL) for Chemical discipline.
Additionally, we have accreditations from ISO 9001:2015.
At KLSPL, we are focused on delivering high quality analytical solutions. KLSPL provides testing and analysis services for companies across the country
Our field of accreditations include: Food and Agriculture Products: Bakery and Confectionary Products, Snacks & Savories, Milk and Dairy Products, Nut and Nut Products, Fruit and Vegetable Products, Honey, Cereals and Pulses, etc.
Certificate-1 and Certificate-2Our state-of-the-art laboratory is equipped with the latest technology and staffed by experienced food scientists who are dedicated to providing accurate and reliable results. We follow strict quality control procedures to ensure that all tests are performed to the highest standards.












